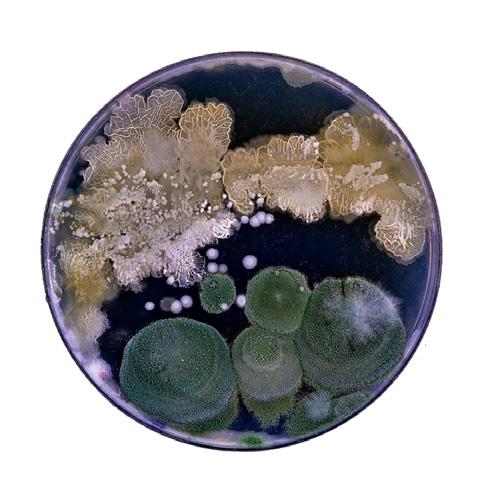
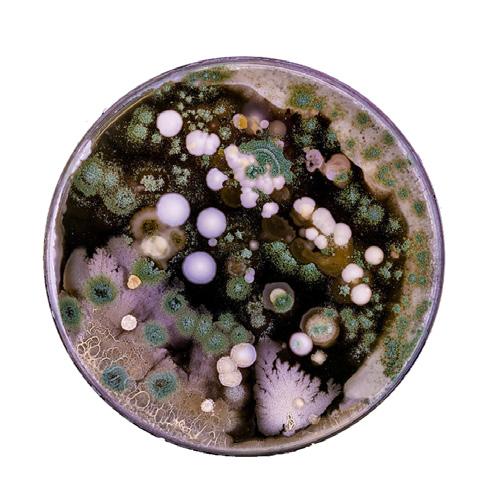

Project Breif: Creating a easily transportable microhome for animal observers that can be placed in different terrains.
My role in this project included producing detailed drawings, creating the exploded axonometric, developing the roof mechanism, completing all renderings, constructing the structural model, and leading the overall concept and design.
Year: October 2025
Status: Personal
Group Competition: Builders Architecture Competitions: Microhome 2025
Team Members: Kaiden Lin, Sophia Zhao, David Gu
Duration: 5 Weeks








Project Breif: To design floating housing for Habitat Against Humanity
Year: Dec 2024
Individual Work
Status: Academic
Subject: Design Studio INT401-01 FA24
Site Location: Garrison Bight,Key West, FL
Tutor: David Ling
Tutor contact: dling@pratt.edu
Duration: 4 Month


SUSTAINABLE DEVELOPMENT GOALS
1 The goal of floating dwelling is to create new infastruction ideas for housing on the water. The design breaks apart and function autonomously which enhances its resilience to climate change, rising sea levels, or other environmental challenges, This adaptability is crucial for developing infrastructure that can withstand changing environmental conditions.
2 Floating dwellings directly contribute to sustainable urban development by creating adaptable, reused material and low-impact housing solutions. The modular and mobile nature of the structures offers resilience in urban design, responding to the needs of expanding populations and the impacts of waste through reusing and recycling structures.
Project Description:
The Floating Dwelling project is a floating community made out of cargo crates and recycled silos. It is designed as a living, growing system that is able to break apart, evolve, and adapt like natural organisms do in their environments.Drawing inspiration from sea moss and its fragmental reproduction process, I designed modular, detachable units that can function autonomously when separated from the larger structure. Just as a small piece of moss can break away and grow into an entirely independent organism. The design of each floating module is inspired by the diatom. The Hub serves as the nucleas of the community bringing in public areas such as a gym, medical room, dining area; bridging around the hub are walkways and semiprivate silos that serve as bridges connecting the floating house to the hub. Within each floating house a boat house can be docked inside creating a detachable structure that can be used for expansion or as a vechile.
Initial Sketches




Concept
Interconnected Docks: A network of floating docks serves as the spine of the floating community. These docks are pathways that also serve as social spaces, creating connection between neighbors and making bridges and walkways into semi private public areas.
Modularity: Each dwelling is composed of individual, self-sufficient units that can be easily detached, reattached, and rearranged. The modular design allows for growth, transformation, and personalization, meeting the evolving needs of the inhabitants.
Exploded View- Vessel

Detachable Structures: Boathouses are stored in individual housing units that can be detached and moved to other locations. This allows residents to relocate by driving out the boathouse, expand rooms into the original unit without disruption to the base structure.
Detachable Surfaces Plan/ Sections

The interior of each floating residence is designed to balance comfort, modularity, and reflect the industrial nature of the architecture that forms; The structure focuses on functionality within compact living spaces. Drawing on the form and function of cargo containers, the homes use recycled shipping containers as structural modules allowing for efficient prefabrication, transport, and environmental sustainability.




Materiality and Structure
Recycled Steel Frames: The core structure is built from repurposed steel shipping containers, providing durability and rigidity while reducing construction waste.
Bamboo and Cork Flooring: Renewable and water-resistant materials like bamboo and cork are used underfoot, offering a warm, tactile contrast to the metallic exteriors.
Marine-Grade Plywood and Aluminum Cladding: These materials are used for cabinetry and wall finishes, chosen for their light weight, resistance to humidity, and long-term resilience in a marine climate.
Triple-Glazed Windows and Skylights: Natural light is maximized through openings that offer expansive views of the water while maintaining thermal efficiency.The doors of the containers are kept as shutters for windows in case of storms/ strong winds.


Render of detachable vessel extension



Bridging the individual dwelling units and public hub are a series of cylindrical modular bridges that serve not just as circulation routes but as miniature community space. These bridges are inspired by the organic adaptability of sea moss and the interlocking symmetry of diatom shells, they are designed to function as both community gardens and docking stations. On the top floor is a layer that serves as a miniature park, below it are seating for neighbours to sit, relax. Bridges are connected to the floating housing on both the top and bottom floor leading to both the first and basement floor levels.
Each cylindrical bridge module incorporates shallow planting beds and integrated irrigation systems, transforming them into floating gardens.
The larger cylindrical silos, inspired by diatom structures, act as communal hubs and embody the biomimetic design ethos of the project:
Storage silos are cylindrical structures, typically 10 to 90 ft (3 to 27 m) in diameter and 30 to 275 ft (10 to 90 m) in height. They can be made of many materials such as wood staves, concrete staves, cast concrete, and steel panels. These silos are built up from the sea bed and serve as a non floating foundation where floating structures can dock around. These hubs serve as public community areas where programs such as a gym, medical room, dining,and lobby area are placed.
Scalable Living: Families can start with a single floating vessel and attach new modules as needed for additional bedrooms, workspaces, or specialized rooms. Rectangular Houseboats are able to be slotted and docked into the floating unit .
Autonomy and Connectivity: Floating Vessels can function independently as well or remain connected via modular bridges or docks, offering flexibility in privacy and communal living.
Dynamic Community Formation: Units can cluster into communities, detach temporarily, or reconfigure spatially depending on social or environmental needs.



Sustainability: Repurposing shipping containers reduces construction waste and gives new life to surplus industrial materials, minimizing the carbon footprint compared to traditional construction.
Compactness & Structural Integrity: Containers are inherently modular, stackable, and designed for transport. Their compact size allows for a clean, space-efficient layout while ensuring dura bility in harsh marine environments.
Ease of Assembly & Mobility: Their uniform dimensions make them ideal for prefabrication and on-site modular assembly, re ducing time and energy spent on construction. when properly retrofitted, they can be made buoyant and flood-resilient—critical for aquatic or flood-prone environments.

The first floor includes docking areas to the house boat which has a mechanical area and boat shed on the exterior docking panels. The interior of the first floor serves as the main bedroom for the floating vessel.
The second floor serves as the main social and work zone, with open living, dining, and cook-

Plan/Perspective View of connection points between vessel and public area








Project Breif: Illustrative Drawings
Year: June 2023
Individual Work
Subject: Language of Drawing II INT234
Tutor: William McLoughlin
Tutor contact: wmclough@pratt.edu
Status: Academic
Duration: 4 Weeks
This project investigates modularity and transformation through a structure inspired by a box that breaks into multiple interlocking pieces, all of which can be reassembled into a compact whole. Drawing influence from the architectural office Nemestudioknown for their conceptual approach across buildings, installations, and speculative design. I produced a series of illustrations that reinterpret their visual language; Key elements from Nemestudios’ work, such as the use of X-ray views, varied lineweights, and layered collage techniques, were employed to explore the spatial logic and graphic potential of the disassembled and reassembled form. The result is a speculative study of form, assembly, and architectural storytelling through drawing.



The interlocking parts of the box were reimagined as architectural components, unfolding into a series of rooms, balconies, and bridges; each piece maintains its identity while contributing to a larger spatial narrative.

Project Breif: To design a visitor attraction where people can enjoy themselves by the water. We decided to propose for a new kind of seaside wellness and education center.
Year: November 2025
Duration:6 Weeks
Status: Personal
Competition: The WAF 2025 Student Charrette Finalist
Team Members: David Gu, Stanley Shih, Kaung Lin, Yumin Hu, Yinuo Zhao, Yiyang Feng
My role in this project included producing all renderings, designing the roof and interior spaces, and creating drawings and visual materials. I was also part of the original three-person team that developed the initial concept, which was shortlisted and later expanded upon with a larger group.
This year’s brief for the Miami WAF Student Charette asked us to design a visitor attraction where people can enjoy themselves by the water. Our team wanted to respond by creating not just a place near the sea, but a place that gently guides people into a relationship with it. We decided to create a wellness center called RAYA that provided people with relaxation by the ocean as well as a opportunity to learn about the surrounding marine life.
We decided to choose the shore of Virginia Beach Miami as a site, aiming to brings tourism to a empty area.The area is known for its large marine life and open beaches. As inspiration for the structure we decided to choose the rough-tail stingray a local creature of the habitat around it that glides seamlessly between sand and sea as a symbol for the building’s journey and purpose. Inspired by the way the stingray buries itself in sand , we wanted to blend the architecture with the land around it creating smooth and natural curvature that blends with the landscape.
Across the world’s coastlines, blue spaces: oceans, beaches, wetlands are proven to support mental restoration, stress reduction, improved mood, and enhanced cognitive functioning. Numerous environmental psychology stuies show that proximity to water lowers cortisol, increases parasympathetic activity, and fosters emotional stability. However, as marine habitats degrade, the quality of the human to sea relationship also erodes. Polluted shorelines, disappearing biodiversity, and hardened coastlines create more superficial encounters with the ocean, rducing opportunities for awe, curiosity, and stewardship. This project responds to that widening experience gap reconnecting humans with the sea through architecture that restores immersion, education, and empathy.and stewardship.




The project begins with a partially embedded structure emerging from the dunes, appearing as though shaped by the same forces that sculpt the coastline. Pathways and park spaces weave seamlessly into the architecture, blurring boundaries between landform and building. This moment represents the land–sea connection, inviting visitors to transition from the familiar terrain of the shore into a designed environment that mirrors the rhythms of the terrain. The inspiration has been taken from the movement, structure, and abilities of the Roughtail stingray.
At the heart of the structure lies the water-therapy wellness center, a collection of hydrotherapy pools, warm and cold plunge rooms, water-pressure massage suites, sensory steam chambers, and restorative treatment spaces. Here, wellness, education, and environment meet, creating a model for tourism that uplifts both people and place. Extending outward into the water, the transparent underwater tunnel forms a gentle, fluid path from the terrestrial world into full marine immersion. Its shape and motion echo the gliding movement of a stingray transitioning from shallow sand to open sea. Within this corridor, changing light, shifting colors, and glimpses of marine life create an experience that gradually envelopes the visitor.





On the roof of the structure, we added pathways and greenery to blend the infastructure with its surroundings. The visual proximity of the sea, many visitors and residents remain passively detached. It is more a structural attachment to the terrain and ocean around.
As visitors enter, the structure descends into the ground, leading them into a calm reception lobby that marks the transition from the bright shoreline into a sheltered wellness environment. From here, the lounge and public reading areas open along the perimeter, while the juice bar and kitchen activate the opposite edge. Moving inward, the atmosphere deepens as guests pass through the locker rooms into a jacuzzi room and arrive at the central pool chamber a sunken, sculptural basin inspired by the stingray’s smooth geometry. Beyond the pool, a focused wellness sequence unfolds with two saunas, a cold plunge. An elevator anchors vertical circulation, while a corridor leads toward the building’s “tail.” Together, the first floor forms a fluid, looping path that echoes the stingray’s gliding movement and blends architecture, water, and landscape into a unified restorative experience.
On the second floor, visitors ascend into a more intimate interior world. A distinct structure nested within the larger architectural shell. The landing opens into a quiet waiting area, which branches into a series of focused therapeutic spaces, including a yoga room, therapy room, and dedicated massage zone arranged around the central core. These wellness rooms are enclosed by a secondary structural frame, creating a sense of retreat suspended above the active programs below.








The tail extends deep beneath the waterline, forming a fully submerged educational passage where architecture and marine ecology merge into a single continuous experience. As visitors move into this space, the ceiling becomes a living lens of ocean water, allowing them to witness rays, swimmers, and shifting surface currents drifting overhead. These movements cast soft, rippling patterns of refracted light across the curved concrete walls, transforming the corridor into a dynamic, ever-changing interior landscape. Along one side, a long panoramic aquarium window reveals the marine species native to the shoreline; stingrays, small schooling fish, and plant life offering an intimate, up-close view of the underwater world that the building seeks to protect. The sculpted, circular thresholds slow the rhythm of movement, encouraging visitors to pause, sit on built-in benches, and engage with educational content integrated into the viewing experience.
As the path continues, the tunnel gradually transitions from the dim, blue-lit underwater environment toward a lighter space where the ceiling thins and natural daylight begins to filter back in. This gentle ascent mirrors the behavior of marine creatures rising toward the surface, creating a spatial narrative that mirrors the ecology on display. Eventually, the tunnel opens outward to reveal an exterior floating pool anchored directly on the ocean’s surface. Here, guests emerge from the quiet, introspective underwater observatory into an open-air environment.

Project Breif: To design a Brooklyn Townhouse for a family of 3
Year: Oct 2023
Duration: 2 Months
Individual Work
Status: Academic
Subject: Design Studio INT301 FA23
Site Location: 262 Bond Street
Tutor: Kevin Cannon
Tutor contact: kcanno78@pratt.edu

Agar Plate

Drawing inspiration from Bacterial Agar Plates and the elongated structure of shotgun homes, this building concept reimagines linear domestic space as a living, reactive environment. Just as agar plates cultivate microbial colonies across a controlled, elongated medium, the architecture uses its narrow footprint as a framework for growth, observation, and interaction. The long, continuous plan becomes a kind of “habitat strip,” where rooms are arranged in sequence like zones of cultured activity, each influencing the next.
Central to the project is the idea that the home functions like an agar plate (a vessel that supports life, reveals patterns, and encourages organic expansion.)
Programmatically, the Public spaces: kitchen, dining, and social areas are situated in front of the central garden which acts as a seperation space between the private bedrooms.The garden Encourages circulation and boundary while maintaining a meditative core. The stair a sculptural, floating wooden element ascends alongside the garden, inviting occupants to rise above the central garden viewing onto the other side of the home.
The interior features a warm, modern palette with natural and materials that create a refined yet inviting atmosphere. Smooth wood flooring runs throughout, adding warmth and texture, while concrete and matte-finished walls introduce a sleek, contemporary edge. Dark wood cabinetry and shelving balance the lighter tones, and glass partitions bring transparency and lightness to the space.



At the heart of the residence is a central garden void, a dramatic architectural gesture that slices vertically and horizontally through the two-story structure. Inspired by Bacterial Agar Plates, where growth radiates outward from a central source and reveals patterns over time, this void acts as the “culturing zone” of the home. Just as an agar plate supports and displays pockets of microbial life, the garden becomes a living nucleus that organizes the spatial volumes around it.
This garden void divides the townhouse into two elongated masses, similar to the linear structure of shotgun homes, allowing light, air, and vegetation to permeate deep into the interior. Acting as a visual and environmental pinpoint, it mediates between private and communal spaces while dissolving the boundary between interior and exterior. At the center, a long hallway with an extended bookshelf seperates the two zones. This corridor functions like a connective “growth channel,” guiding movement along the home’s linear axis. Paneled windows along the hallway can slide open into the gaden, transforming the threshold into an outdoor reading deck that invites natural ventilation, filtered sunlight, and moments of quiet observation


At the center, a long hallway with an extended bookshelf anchors the two zones. This corridor functions like a connective “growth channel,” guiding movement along the home’s linear axis. Large openings along the hallway can fold open into the garden, transforming the threshold into an outdoor reading deck that invites natural ventilation, filtered sunlight, and moments of quiet observation
The second floor splits two functionality for programs. The front side of the home viewing the street is dedicated to a Hobby room and two home offices giving views onto the street. Further away from street noise on the back side of the home is the bedroom.
From circular windows that offer focused glimpses outward to linear glazed cutouts that stretch across the rammed earth walls, each opening is strategically placed to enhance both illumination and spatial experience. Inspired by the punctures, petri-dish cutouts, and radial growth patterns of Bacterial Agar Plates, these apertures mimic the way colonies reveal themselves through distinct shapes and transparencies.

Project Breif: To design a office for the International Living Future Institute
Year: Oct 2023
Duration: 2 Months
Individual Work
Status: Academic
Subject: Design Studio INT301 FA23
Site Location: 141 Flushing Avenue, Brooklyn Navy Yard
Tutor: Kevin Cannon
Tutor contact: kcanno78@pratt.edu
The space is inspired by the waterfront of the Navy yard, It unfolds like water: fluid, calming, and. Drawing on principles of biomimicry, the interior uses flowing forms and curved partitions that echo the natural ripples of the Brooklyn Navy Yard waterfront. Recycled glass tiles shimmer under natural light, creating a meditative play of color that energizes while soothing.
Workstations are configured in open, non-hierarchical clusters, allowing for fluid communication and collaboration. Materials are locally sourced or post-consumer recycled, including compressed plastic panels that are sculpted into hanging structures. These elements function dually as acoustic dampeners and visual metaphors for the layered strata of coastal geology.


Reclaimed wood plays a central role in the material identity of the office, serving as both a sustainable choice and a variation in texture. Sourced from deconstructed buildings and salvaged timber, the wood introduces texture, and a sense of continuity with the past. Its naturally weathered surfaces, grain variations, are intentionally preserved, adding depth and authenticity to the space. Used across flooring, wall cladding, furniture elements. Beyond aesthetics, its presence embodies the project’s core values, reducing material waste, celebrating reuse, and reinforcing a design language that is rooted in ecological responsibility and material storytelling.
Greenery is placed around the office space to support well-being and emotional balance. The plants purify the air, reduce ambient noise, and create biophilic moments of visual rest throughout the day. These green elements help transform the office into a healthier, more restorative place to work.




This project envisions an office environment where design becomes a tool for healing of both people and the planet. Created for a company committed to radically transforming the built environment, the office reflects an ethos centered on sustainability, well-being, and systemic change. The design decisions aims to eliminate harm and realign architecture with the health of nature and of all beings.

Color and light are choreographed to support cognitive and emotional states throughout the day. Drawing from marine ecosystems, the palette features gradients of soft blues, deep greens, and cool neutrals, selected to reduce stress and enhance focus. Task areas are brightly lit with daylight and supported by energy-efficient ambient lighting, while retreat spaces use dimmer, more immersive tones to support mental restoration.





Program List:

Ensuring that every employee has access to daylight is a core design principle of the office. Workstations are placed along the perimeter to benefit from window exposure, and each desk is oriented to maximize natural light throughout the day. Glass walls, transparent partitions, and translucent dividers help carry daylight deep into the interior, creating visual continuity while allowing glimpses into active work zones such as the material lab and fabrication lab. Private offices and meeting rooms use glass screen doors to maintain this openness and light flow without compromising functionality. For focused tasks, enclosed privacy pods provide quiet, sound-controlled environments while still remaining visually connected to the broader workspace.

Biophilia Collaborative area
The Biophilia Collaborative area gives a space for employees to sit and work in groups of 4. The large couch seating with plant life allows for more casual, non-desk work. The biophilia structure looks forward towards the fabrication labs and material labs’ open glass walls, giving employees the opportunity to fuel creativity by seeing others work.
The rear wall serves as a focal point and a social common area where employees are able to work/collaborate. white reclaimed plastics reflect light and bring color which contrast, plants grow around the irregular curves enhancing the appeal and attraction of the space.
This entry-level environment on the first floor combines a bookshop, quiet meeting pods, and a sculptural spiral staircase, creating a multi-functional public area that supports curiosity, retreat, and gives clients and guests a area to relax while being seperated from the main working area.


Sustainable materials like compressed plastic are shaped into sweeping, curved sculptural elements that hang gracefully from the ceiling, doubling as high-performance acoustic panels. Their fluid geometry conceals integrated ventilation channels, allowing the mechanical systems to blend seamlessly into the design. When recessed lighting washes over these forms, they cast dynamic reflections and soft layered shadows that animate the workspace throughout the day. The curated color palette introduces subtle sprinkles of vibrant hues within an otherwise cool, calming environment creating a balanced visual rhythm that ties the curvature, lighting, and materiality together.



Project Breif: Our studio built a full-scale model made out of orgami fabrication techniques; the project was centered on the theme of escape. Designed as a small projector room, the structure aimed to evoke feelings of isolation and disconnection. My Role in this project was to help with Joinery design, fabrication, model making, and visuals.
Year: January 2023
Duration: 2 Months
Group project with Studio Class: INT202-07
Status: Academic
Escape, in this context, is a form of denial, of attention, information, and responsibility. In a world overwhelmed by constant connectivity, rapid change, and global crises, people often feel anxious and disconnected. Despite the rise of digital platforms, meaningful human connection remains elusive.
The initiation of this project comes from the large amount of plotting paper used daily. Used once and discarded. Through interviewing session with all printing center at Pratt, every month, the letter paper alone consumes 121000 sheets. A largest percentage of printing happened in the Machinery lab, which prints all the time for the whole school and faculty. And among the student’s plotting, our interior design department is the largest consumer.
This installation was inspired by sci-fi escape pods, reimagined through our own design. We challenged ourselves to construct a spherical form using flat white paper, developing a custom joint system to secure the base tightly.
The space is sized to allow a person to sit, stand, and meditate, It offers both physical freedom and mental escape. It is a space for detachment from negative thoughts and for inner transformation. The modules and voids reflect meditation wavelengths, inviting the user into a spiritual experience.
Dome represent emptiness, not as absence, but as a state of heightened brain activity and creative energy. Sharp edges of the shell symbolize consciousness in escape, while folded forms reflect cognitive waves and abstract thought, allowing ideas to flow freely in space.





Project Breif: Commercial Project, Production of construction plans
Year: Nov 2024
Duration: 4 Months
Status: Academic
Group Members: Sophia Zhao, Judy Liu, David Gu
Subject: Working Set SP25INT441
Site Location: 191 Smith Street
Tutor: Eric Ansel
Tutor contact: eansel@pratt.edu
Set on 191 smith street, this bar reimagines traditional Chinese medicine for a contemporary younger audiences, offering a vibrant yet tranquil space that fuses health, herbalism, and relaxation.
Guests can experience pulse diagnosis to receive personalized herbal wine and cocktail recommendations tailored to their health needs.
By harmonizing the serenity of Chinese medicine with nightlife, the space makes drinking into a journey of cultural discovery and wellness. This Project was more focused on creating acurate and detailed construction plans; the renderings were later reworked by me to fit the concept and material palette better.
For this group project I was in charge of creating visual renderings, modeling, material planning. I also created Schematics such as Longitudinal sections, Electrical planning, and details.
Renderings : David Gu


Analysis/ Material Planning


Bar Renderings: David Gu


Furniture Plan
Our group collaborated on developing a comprehensive set of architectural plans and drawings for a proposed project. The work involved coordinated efforts in conceptual planning, technical development, and final presentation documentation.

Removal Plan


Longitudinal Section
Construction Plan












I focused on detailed elevations, sections, electrical layouts, and sectional studies for cabinetry, walls, shelving and the bar, as well as producing renders and contributing to the BIM model.

WEBSITE: GU-DESIGN.NET
EMAIL: Davidgux12@gmail.com
TELEPHONE: +1(718)5785389
© 2025 Chenyi Gu All Rights Reserved